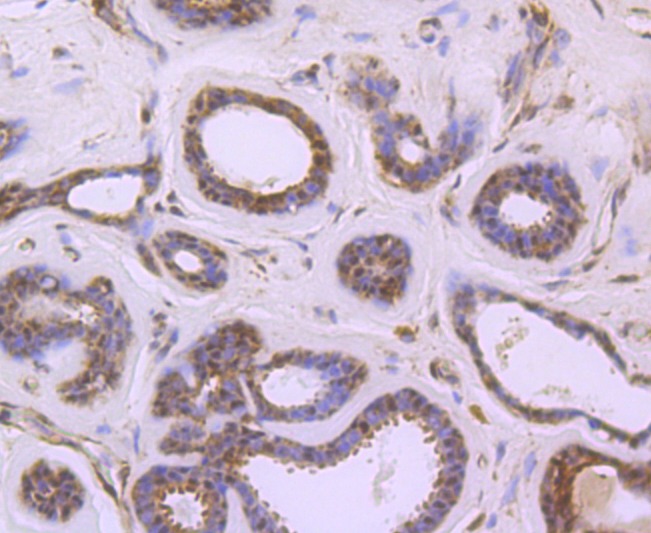
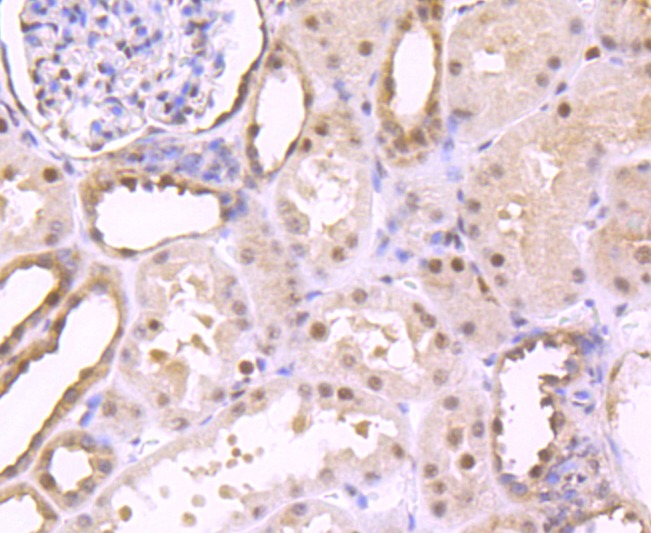

购物车
 您的购物车当前为空
您的购物车当前为空
Anti-S1PR1 Antibody (9T480) 是一种 Rabbit 抗体,靶向 S1PR1。Anti-S1PR1 Antibody (9T480) 可用于 FCM,ICC/IF,IHC,WB。
别名 Sphingosine 1-phosphate receptor Edg-1, Sphingosine 1-phosphate receptor 1, S1PR 1, S1P1, S1P receptor Edg-1, S1P receptor 1, Endothelial differentiation G-protein coupled receptor 1, EDG1, CHEDG1, CD antigen CD363
Anti-S1PR1 Antibody (9T480) 是一种 Rabbit 抗体,靶向 S1PR1。Anti-S1PR1 Antibody (9T480) 可用于 FCM,ICC/IF,IHC,WB。
| 规格 | 价格 | 库存 | 数量 |
|---|---|---|---|
| 50 μL | ¥ 1,495 | 5日内发货 | |
| 100 μL | ¥ 2,480 | 5日内发货 |
TargetMol的所有产品仅用作科学研究或药证申报,不能被用于人体,我们不向个人提供产品和服务。请您遵守承诺用途,不得违反法律法规规定用于任何其他用途。
| 产品描述 | Anti-S1PR1 Antibody (9T480) is a Rabbit antibody targeting S1PR1. Anti-S1PR1 Antibody (9T480) can be used in FCM,ICC/IF,IHC,WB. |
| 别名 | Sphingosine 1-phosphate receptor Edg-1, Sphingosine 1-phosphate receptor 1, S1PR 1, S1P1, S1P receptor Edg-1, S1P receptor 1, Endothelial differentiation G-protein coupled receptor 1, EDG1, CHEDG1, CD antigen CD363 |
| Ig Type | IgG |
| 克隆号 | 9T480 |
| 反应种属 | Human,Mouse,Rat |
| 验证活性 | 1. Western blot analysis of EDG1 on SH-SY5Y cells lysates using anti-EDG1 antibody at 1/1,000 dilution. 2. Immunohistochemical analysis of paraffin-embedded human breast carcinoma tissue using anti-EDG1 antibody. Counter stained with hematoxylin. 3. Immunohistochemical analysis of paraffin-embedded human liver tissue using anti-EDG1 antibody. Counter stained with hematoxylin. 4. Immunohistochemical analysis of paraffin-embedded human kidney tissue using anti-EDG1 antibody. Counter stained with hematoxylin. 5. Immunohistochemical analysis of paraffin-embedded mouse brain tissue using anti-EDG1 antibody. Counter stained with hematoxylin. 6. Immunohistochemical analysis of paraffin-embedded mouse herat tissue using anti-EDG1 antibody. Counter stained with hematoxylin. 7. ICC staining EDG1 in HepG2 cells (red). The nuclear counter stain is DAPI (blue). Cells were fixed in paraformaldehyde, permeabilised with 0.25% Triton X100/PBS. 8. ICC staining EDG1 in HUVEC cells (red). The nuclear counter stain is DAPI (blue). Cells were fixed in paraformaldehyde, permeabilised with 0.25% Triton X100/PBS. 9. ICC staining EDG1 in SH-SY5Y cells (red). The nuclear counter stain is DAPI (blue). Cells were fixed in paraformaldehyde, permeabilised with 0.25% Triton X100/PBS. 10. Flow cytometric analysis of Jurkat cells with EDG1 antibody at 1/50 dilution (red) compared with an unlabelled control (cells without incubation with primary antibody; black). Alexa Fluor 488-conjugated goat anti rabbit IgG was used as the secondary antibody. 11. All lanes: EDG1 Rabbit mAb at 1/1000 dilution, Lane 1: HUVEC whole cell lysates, Lane 2: JK whole cell lysates, Lane 3: HT29 whole cell lysates, Lane 4: Rat brain lysates Lysates at 20 μg per lane. Secondary All lanes: Goat Anti-Rabbit IgG H&L (HRP) at 1/10000 dilution, Predicted band size: 43 kDa, Observed band size: 43-50 kDa, Exposure time: 5 seconds. |
| 应用 | FCMICC/IFIHCWB |
| 推荐剂量 | WB: 1:1000-5000; IHC: 1:50-200; ICC/IF: 1:100-500; FCM: 1:50-100 |
| 抗体种类 | Monoclonal |
| 宿主来源 | Rabbit |
| 构建方式 | Recombinant Antibody |
| 纯化方式 | ProA affinity purified |
| 性状 | Liquid |
| 缓冲液 | 1*TBS (pH7.4), 1%BSA, 40%Glycerol. Preservative: 0.05% Sodium Azide. |
| 研究背景 | The EDG (endothelial differentiation gene) family of G protein coupled receptors consists of eight family members that bind lysophospholipid (LPL) mediators, including sphingosine-1-phosphate (SPP) and lysophosphatidic acid (LPA). EDG-1, EDG-3, EDG-5 (also designated H218 and AGR16) and EDG-8 bind SPP with high affinity. EDG-6 is a low affinity receptor for SPP. LPA preferentially binds to EDG-2, EDG-4 and EDG-7. The EDG receptors couple to multiple G proteins to signal through Ras, MAP kinase, Rho, Phospholipase C or other tyrosine kinases, which lead to cell survival, growth, migration and differentiation. EDG-1 signals through Gi proteins to activate Akt and is expressed in glioma cells. EDG-2 is expressed in brain, especially in white matter tract regions, while EDG-3 is expressed in cardiovascular tissue and in cerebellum. EDG-4 is highly expressed on leukocytes and brain, and EDG-5 has wide tissue distribution, including cardiovascular tissue and brain. EDG-6, which is expressed in lymphoid and hematopoietic tissues and in lung, signals through G(i/o) proteins, which activate growth related pathways |
| 偶联 | Unconjugated |
| 免疫原 | Recombinant Protein |
| Uniprot ID |
| 分子量 | Theoretical: 43 kDa. |
| 储存方式 | Store at -20°C or -80°C for 12 months. Avoid repeated freeze-thaw cycles. |
| 运输方式 | Shipping with blue ice. |